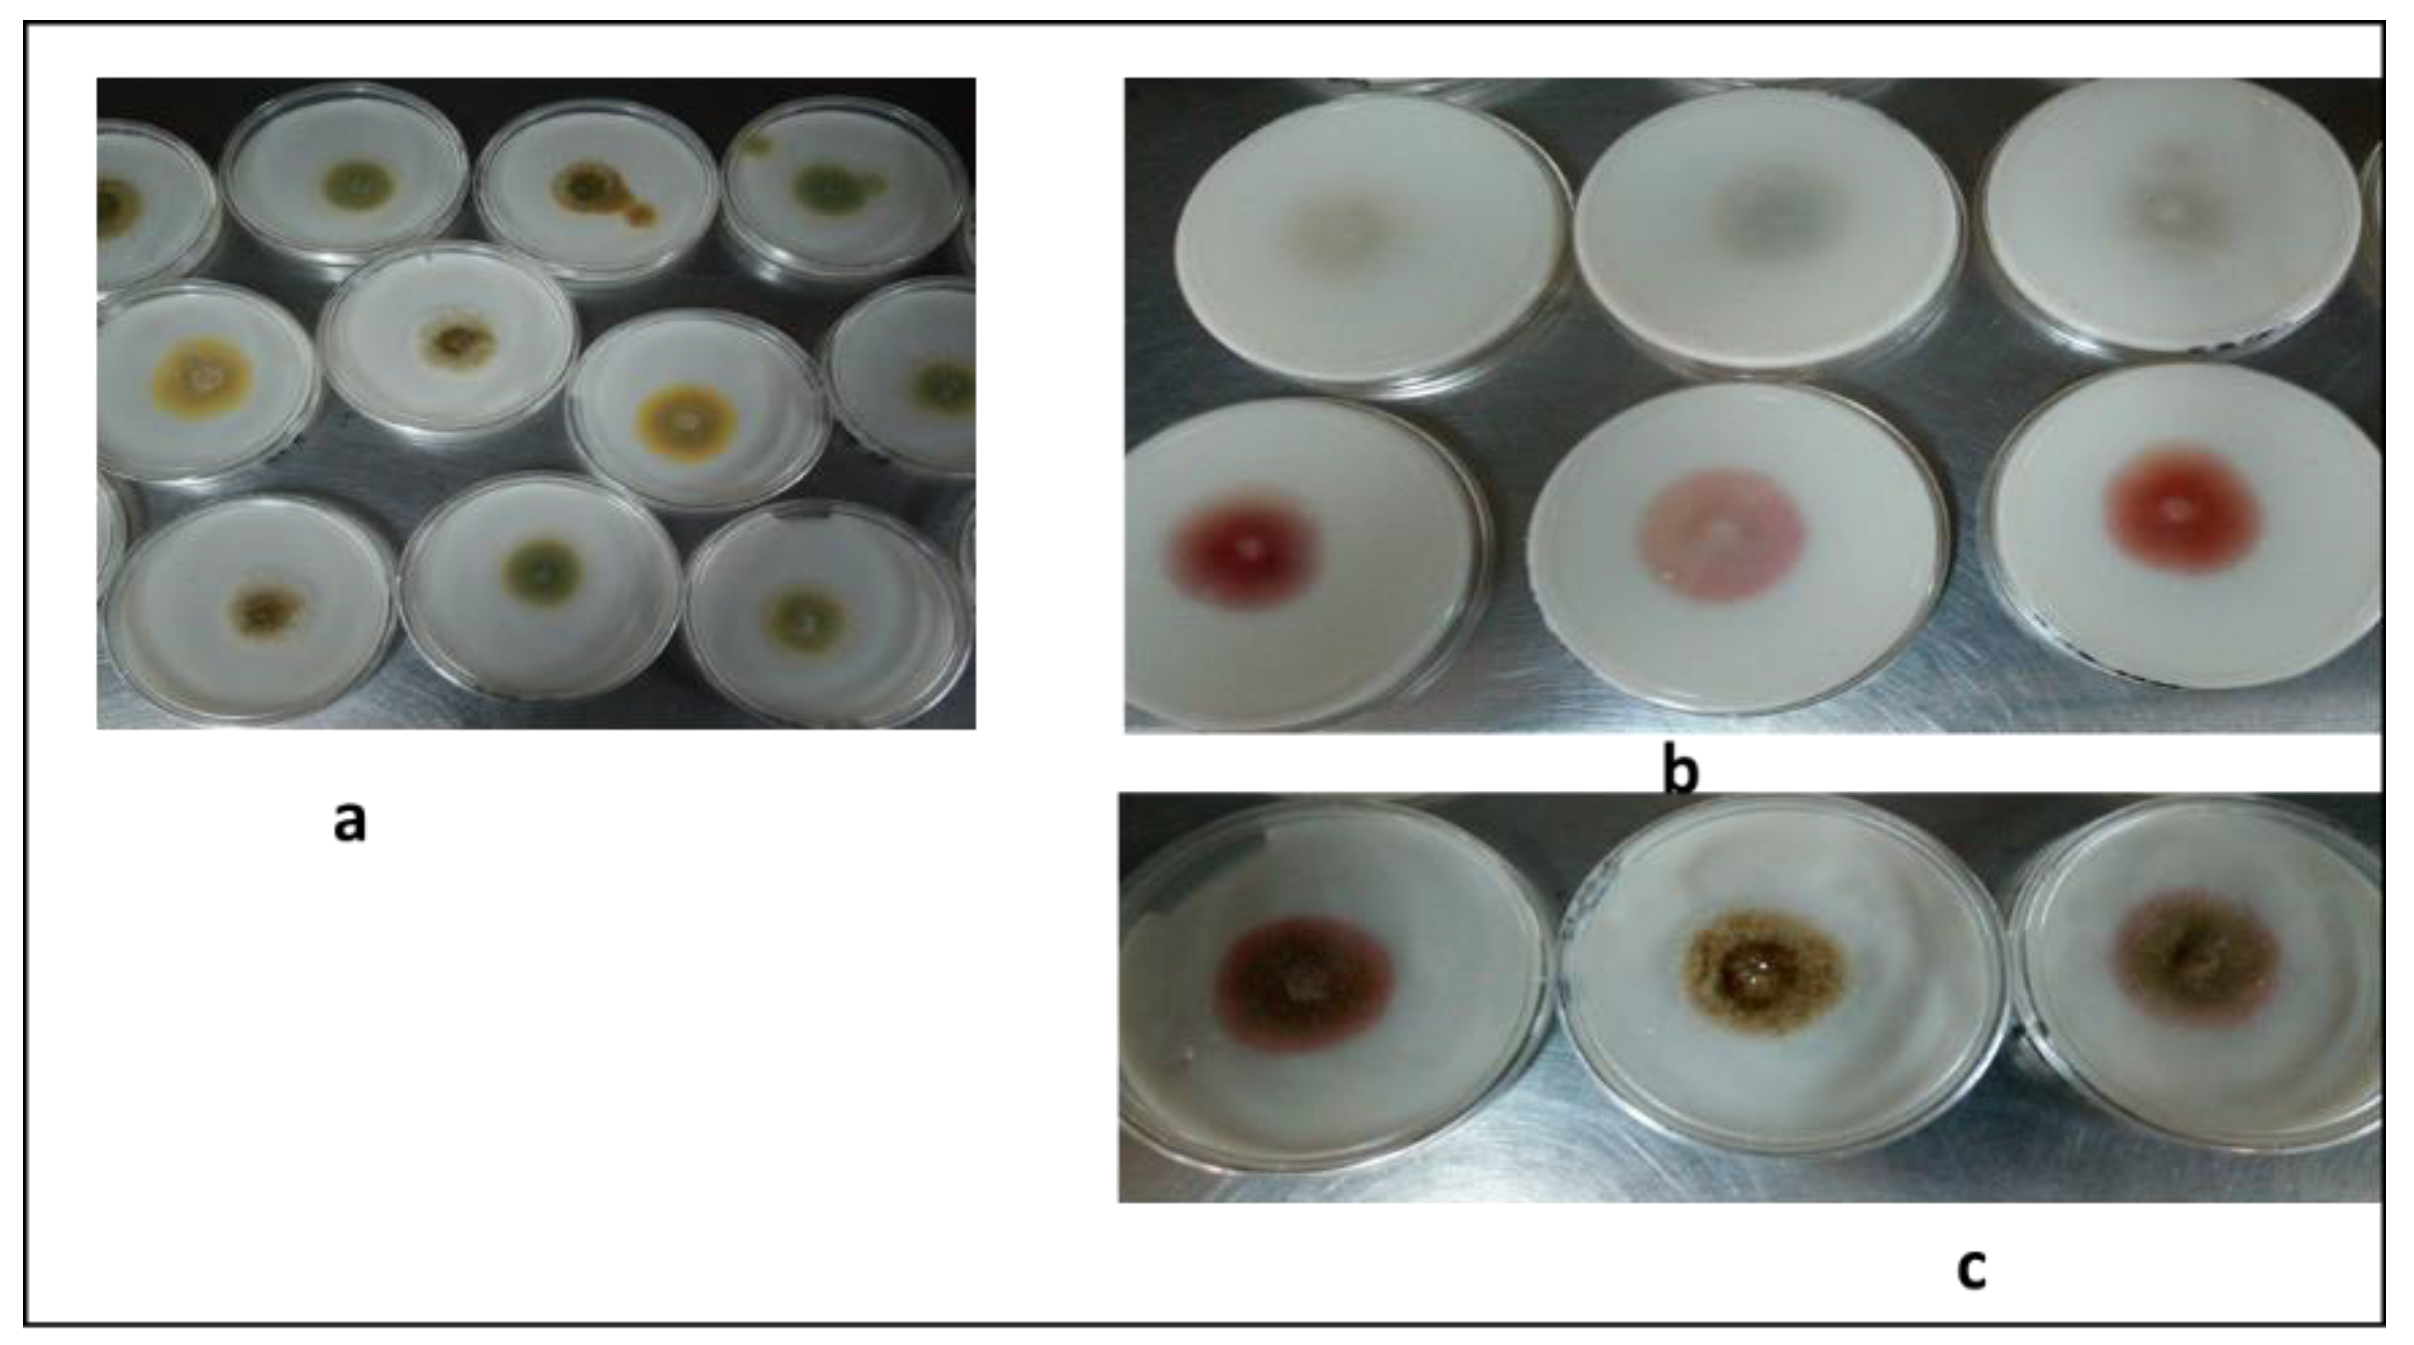
Insects 11 00277 g002 Insects 11 00277 g002

Evaluation of the Potential of Fungal Biopesticides for the Biological Control of the Seed Bug, Elasmolomus pallens (Dallas) (Hemiptera: Rhyparochromidae)
Abstract
1. Introduction
2. Materials and Methods
2.1. Bugs Collection and Rearing
Identification of Bug Species
2.2. Fungal Isolates
2.3. Microscopic Observation
2.4. In Vitro Screening of Isolates for Aflatoxins Production
2.5. Genomic DNA Extraction and Polymerase Chain Reaction (PCR)
2.6. Phylogenetic Analysis
2.7. Fungal Conidial Preparation
2.8. Conidial Viability
2.8.1. Single-Dose Virulence Assessment Bioassay
2.8.2. Multiple-Dose Virulence Bioassay
2.9. Data Analysis
3. Results
3.1. Molecular and Morphological Identification of E. Pallens
3.2. Fungal Isolation and Identification
3.3. In Vitro Screening of Isolates for Aflatoxins Production
3.4. Phylogeny of the Fungal Isolates
3.5. Single-Dose Virulence Assessment Bioassay
3.6. Multiple-Dose Virulence Bioassay
4. Discussion
5. Conclusions
Author Contributions
Funding
Acknowledgments
Conflicts of Interest
References
- Weirauch, C.; Schuh, R.T. Systematics and Evolution of Heteroptera: 25 Years of Progress. Annu. Rev. Entomol. 2011, 56, 487–510. [Google Scholar] [CrossRef] [PubMed]
- Mohamed, S.K.; Allah, S.M.G. Taxonomic review of family Rhyparochromidae (Hemiptera: Lygaeoidea) from Egypt. Egypt. J. Exp. Biol. (Zool.) 2013, 9, 33–60. [Google Scholar]
- Tomokuni, M. Inventory research on Rhyparochromidae (Insecta: Heteroptera) in Sarawak, Malaysia, with a checklist of the Family known from Borneo. Mem. Natl. Mus. Nat. Sci. Tokyo 2010, 46, 13–24. [Google Scholar]
- Schaefer, C.W.; Panizzi, A.R. Heteroptera of Economic Importance; CRC Press: Boca Raton, FL, USA, 2000. [Google Scholar]
- Kinati, K. The survey on field insect pests of sesame (Sesamum indicum L.) in east wollega and horo guduru wollega zones, west Oromia, Ethiopia. Int. J. Entomol. Res. 2017, 2, 22–26. [Google Scholar]
- Ranga Rao, G.V.; Rameshwar Rao, V.; Nigam, S.N. Post-Harvest Insect Pests of Groundnut and Their Management; International Crops Research Institute for the Semi-Arid Tropics: Andhra Pradesh, India, 2010. [Google Scholar]
- Dabhade, P.; Bapodra, J.; Jethva, D.; Rathod, R.; Dabhi, M. Estimation of yield losses due to major insect pests of groundnut in gujarat. Legume Res. Int. J. 2012, 35, 354–356. [Google Scholar]
- Samaila, A.; Malgwi, A.; Degri, M. Damage and Loss Caused by’ Offa’ (Rhyparochromus littoralis dist.) [Heteroptera: Lygaeidae] on Groundnut in Song Local Government Area of Adamawa State, Nigeria. Am. J. Exp. Agric. 2014, 4, 1616. [Google Scholar] [CrossRef]
- Senthil-Nathan, S. Natural Pesticide Research; Elsevier: Amsterdam, The Netherlands, 2018. [Google Scholar]
- Pretty, J.; Bharucha, Z. Integrated pest management for sustainable intensification of agriculture in Asia and Africa. Insects 2015, 6, 152–182. [Google Scholar] [CrossRef]
- Hussain, A.; Rizwan-ul-Haq, M.; Al-Ayedh, H.; AlJabr, A.M. Susceptibility and immune defence mechanisms of Rhynchophorus ferrugineus (Olivier) (Coleoptera: Curculionidae) against entomopathogenic fungal infections. Int. J. Mol. Sci. 2016, 17, 1518. [Google Scholar] [CrossRef]
- Lacey, L.A.; Grzywacz, D.; Shapiro-Ilan, D.I.; Frutos, R.; Brownbridge, M.; Goettel, M.S. Insect pathogens as biological control agents: Back to the future. J. Invertebr. Pathol. 2015, 132, 1–41. [Google Scholar] [CrossRef]
- Hussain, A.; Tian, M.-Y.; Ahmed, S.; Shahid, M. Current status of entomopathogenic fungi as mycoinecticides and their inexpensive development in liquid cultures. In Zoology; InTech: Rijeka, Croatia, 2012. [Google Scholar]
- Butt, T.; Coates, C.; Dubovskiy, I.; Ratcliffe, N. Entomopathogenic fungi: New insights into host-pathogen interactions. In Advances in Genetics; Elsevier: Amsterdam, The Netherlands, 2016; Volume 94, pp. 307–364. [Google Scholar]
- Lee, S.J.; Kim, S.; Yu, J.S.; Kim, J.C.; Nai, Y.-S.; Kim, J.S. Biological control of Asian tiger mosquito, Aedes albopictus (Diptera: Culicidae) using Metarhizium anisopliae JEF-003 millet grain. J. Asia-Pac. Entomol. 2015, 18, 217–221. [Google Scholar] [CrossRef]
- Jaronski, S.T. Ecological factors in the inundative use of fungal entomopathogens. BioControl 2010, 55, 159–185. [Google Scholar] [CrossRef]
- Vega, F.E.; Goettel, M.S.; Blackwell, M.; Chandler, D.; Jackson, M.A.; Keller, S.; Koike, M.; Maniania, N.K.; Monzon, A.; Ownley, B.H. Fungal entomopathogens: New insights on their ecology. Fungal Ecol. 2009, 2, 149–159. [Google Scholar] [CrossRef]
- Jaber, L.R.; Ownley, B.H. Can we use entomopathogenic fungi as endophytes for dual biological control of insect pests and plant pathogens? Biol. Control 2018, 116, 36–45. [Google Scholar] [CrossRef]
- USDA. Collection of Enntomopathogenic Fungal Cultures; Agriculture, U.S.D.A: Calverton, NY, USA, 2014.
- Quinelato, S.; Golo, P.S.; Perinotto, W.M.; Sá, F.A.; Camargo, M.G.; Angelo, I.C.; Moraes, A.M.; Bittencourt, V.R. Virulence potential of Metarhizium anisopliae sl isolates on Rhipicephalus (Boophilus) microplus larvae. Vet. Parasitol. 2012, 190, 556–565. [Google Scholar] [CrossRef]
- Jaber, L.R.; Enkerli, J. Effect of seed treatment duration on growth and colonization of Vicia faba by endophytic Beauveria bassiana and Metarhizium brunneum. Biol. Control 2016, 103, 187–195. [Google Scholar] [CrossRef]
- Karthi, S.; Vaideki, K.; Shivakumar, M.S.; Ponsankar, A.; Thanigaivel, A.; Chellappandian, M.; Vasantha-Srinivasan, P.; Muthu-Pandian, C.K.; Hunter, W.B.; Senthil-Nathan, S. Effect of Aspergillus flavus on the mortality and activity of antioxidant enzymes of Spodoptera litura Fab. (Lepidoptera: Noctuidae) larvae. Pestic. Biochem. Physiol. 2018, 149, 54–60. [Google Scholar] [CrossRef]
- Seye, F.; Bawin, T.; Boukraa, S.; Zimmer, J.Y.; Ndiaye, M.; Delvigne, F.; Francis, F. Effect of entomopathogenic Aspergillus strains against the pea aphid, Acyrthosiphon pisum (Hemiptera: Aphididae). Appl. Entomol. Zool. 2014, 49, 453–458. [Google Scholar] [CrossRef]
- Scully, L.R.; Bidochka, M.J. Serial passage of the opportunistic pathogen Aspergillus flavus through an insect host yields decreased saprobic capacity. Can. J. Microbiol. 2005, 51, 185–189. [Google Scholar] [CrossRef]
- Gupta, A.; Gopal, M. Aflatoxin production by Aspergillus flavus isolates pathogenic to coconut insect pests. World J. Microbiol. Biotechnol. 2002, 18, 329. [Google Scholar] [CrossRef]
- Zorzete, P.; Baquião, A.C.; Atayde, D.D.; Reis, T.A.; Gonçalez, E.; Corrêa, B. Mycobiota, aflatoxins and cyclopiazonic acid in stored peanut cultivars. Food Res. Int. 2013, 52, 380–386. [Google Scholar] [CrossRef]
- Criseo, G.; Bagnara, A.; Bisignano, G. Differentiation of aflatoxin-producing and non-producing strains of Aspergillus flavus group. Lett. Appl. Microbiol. 2001, 33, 291–295. [Google Scholar] [CrossRef] [PubMed]
- Ezekiel, C.; Udom, I.; Frisvad, J.C.; Adetunji, M.; Houbraken, J.; Fapohunda, S.; Samson, R.; Atanda, O.; Agi-Otto, M.; Onashile, O. Assessment of aflatoxigenic Aspergillus and other fungi in millet and sesame from Plateau State, Nigeria. Mycology 2014, 5, 16–22. [Google Scholar] [CrossRef] [PubMed]
- Mamo, F.T.; Shang, B.; Selvaraj, J.N.; Wang, Y.; Liu, Y. Isolation and characterization of Aspergillus flavus strains in China. J. Microbiol. 2018, 56, 119–127. [Google Scholar] [CrossRef] [PubMed]
- Humphrey, J. Food safety, trade, standards and the integration of smallholders into value chains: A review of the literature. Ifad Res. Ser. 2017, 11, 1–72. [Google Scholar]
- Degola, F.; Berni, E.; Restivo, F.M. Laboratory tests for assessing efficacy of atoxigenic Aspergillus flavus strains as biocontrol agents. Int. J. Food Microbiol. 2011, 146, 235–243. [Google Scholar] [CrossRef]
- Orduño-Cruz, N.; Guzmán-Franco, A.; Rodríguez-Leyva, E.; Alatorre-Rosas, R.; González-Hernández, H.; Mora-Aguilera, G. In vivo selection of entomopathogenic fungal isolates for control of Diaphorina citri (Hemiptera: Liviidae). Biol. Control 2015, 90, 1–5. [Google Scholar] [CrossRef]
- Santi, L.; e Silva, L.A.D.; da Silva, W.O.B.; Corrêa, A.P.F.; Rangel, D.E.N.; Carlini, C.R.; Schrank, A.; Vainstein, M.H. Virulence of the entomopathogenic fungus Metarhizium anisopliae using soybean oil formulation for control of the cotton stainer bug, Dysdercus peruvianus. World J. Microbiol. Biotechnol. 2011, 27, 2297–2303. [Google Scholar] [CrossRef]
- Flores-Villegas, A.L.; Cabrera-Bravo, M.; Toriello, C.; Bucio-Torres, M.I.; Salazar-Schettino, P.M.; Cordoba-Aguilar, A. Survival and immune response of the Chagas vector Meccus pallidipennis (Hemiptera: Reduviidae) against two entomopathogenic fungi, Metarhizium anisopliae and Isaria fumosorosea. Parasit Vectors 2016, 9, 176. [Google Scholar] [CrossRef]
- FitzGerald, V.C.C.; Hill, M.P.; Moore, S.D.; Dames, J.F. Screening of entomopathogenic fungi against citrus mealybug, Plannococcus citri (Hemiptera: Pseudococcidae). Afr. Entomol. 2016, 24, 343–351. [Google Scholar] [CrossRef]
- Khosravi, R.; Sendi, J.J.; Zibaee, A.; Shokrgozar, M.A. Virulence of four Beauveria bassiana (Balsamo) (Asc., Hypocreales) isolates on rose sawfly, Arge rosae under laboratory condition. J. King Saud Univ. Sci. 2015, 27, 49–53. [Google Scholar] [CrossRef]
- Tembe, S.; Shouche, Y.; Ghate, H. DNA barcoding of Pentatomomorpha bugs (Hemiptera: Heteroptera) from Western Ghats of India. Meta Gene 2014, 2, 737–745. [Google Scholar] [CrossRef] [PubMed]
- Katinka, V. Taxonomy of the tribe Ozophorini (Lygaeoidea: Rhyparochromidae) in Oriental Region. Ph.D. Thesis, University of Pannonia, Veszprém, Hungary, 2016. [Google Scholar]
- Woo, P.C.; Ngan, A.H.; Chui, H.-K.; Lau, S.K.; Yuen, K.-Y. Agar block smear preparation: A novel method of slide preparation for preservation of native fungal structures for microscopic examination and long-term storage. J. Clin. Microbiol. 2010, 48, 3053–3061. [Google Scholar] [CrossRef] [PubMed]
- White, T.J.; Bruns, T.; Lee, S.; Taylor, J. Amplification and direct sequencing of fungal ribosomal RNA genes for phylogenetics. Pcr Protoc. A Guide Methods Appl. 1990, 18, 315–322. [Google Scholar]
- Sun, X.; Yan, W.; Qin, W.; Zhang, J.; Niu, X.; Ma, G.; Li, F. Screening of tropical isolates of Metarhizium anisopliae for virulence to the red palm weevil Rhynchophorus ferrugineus Olivier (Coleoptera: Curculionidae). SpringerPlus 2016, 5, 1100. [Google Scholar] [CrossRef]
- Kumar, S.; Stecher, G.; Tamura, K. MEGA7: Molecular evolutionary genetics analysis version 7.0 for bigger datasets. Mol. Biol. Evol. 2016, 33, 1870–1874. [Google Scholar] [CrossRef]
- Carrillo, D.; Dunlap, C.; Avery, P.; Navarrete, J.; Duncan, R.; Jackson, M.; Behle, R.; Cave, R.; Crane, J.; Rooney, A. Entomopathogenic fungi as biological control agents for the vector of the laurel wilt disease, the redbay ambrosia beetle, Xyleborus glabratus (Coleoptera: Curculionidae). Biol. Control 2015, 81, 44–50. [Google Scholar] [CrossRef]
- Resquín-Romero, G.; Garrido-Jurado, I.; Quesada-Moraga, E. Combined use of entomopathogenic fungi and their extracts for the control of Spodoptera littoralis (Boisduval) (Lepidoptera: Noctuidae). Biol. Control 2016, 92, 101–110. [Google Scholar] [CrossRef]
- Abbott, W. A method of computing the effectiveness of an insecticide. J. Econ. Entomol 1925, 18, 265–267. [Google Scholar] [CrossRef]
- Throne, J.E.; Weaver, D.K.; Chew, V.; Baker, J.E. Probit analysis of correlated data: Multiple observations over time at one concentration. J. Econ. Entomol. 1995, 88, 1510–1512. [Google Scholar] [CrossRef]
- Geiser, D.M.; Aoki, T.; Bacon, C.W.; Baker, S.E.; Bhattacharyya, M.K.; Brandt, M.E.; Brown, D.W.; Burgess, L.W.; Chulze, S.; Coleman, J.J. One fungus, one name: Defining the genus Fusarium in a scientifically robust way that preserves longstanding use. Phytopathology 2013, 103, 400–408. [Google Scholar] [CrossRef]
- Gardezi, S.R.A. Studies on the application of fungi and bacteria controlling insect pests in Azad Jammu and Kashmir, Pakistan. Arch. Phytopathol. Plant Prot. 2006, 39, 49–67. [Google Scholar] [CrossRef]
- Balogun, S.; Fagade, O. Entomopathogenic fungi in population of Zonocerus variegatus (l) in Ibadan, south west, Nigeria. Afr. J. Biotechnol. 2004, 3, 382–386. [Google Scholar]
- Domsch, K.H.; Gams, W.; Anderson, T.-H. Compendium of Soil Fungi; Academic Press Ltd.: London, UK, 1980; Volume 1. [Google Scholar]
- Yip, H.; Rath, A.; Koen, T. Characterization of Metarhizium anisopliae isolates from Tasmanian pasture soils and their pathogenicity to redheaded cockchafer (Coleoptera: Scarabaeidae: Adoryphorus couloni). Mycol. Res. 1992, 96, 92–96. [Google Scholar] [CrossRef]
- Elmer, W.H. A single mating population of Gibberella fujikuroi (Fusarium proliferatum) predominates in asparagus fields in Connecticut, Massachusetts, and Michigan. Mycologia 1995, 87, 68–71. [Google Scholar] [CrossRef]
- Assaf, L.H.; Haleem, R.A.; Abdullah, S.K. Association of entomopathogenic and other opportunistic fungi with insects in dormant locations. Jordan J. Biol. Sci. 2011, 147, 1–6. [Google Scholar]
- NouriAiin, M.; Askary, H.; Imani, S.; Zare, R. Isolation and characterization of entomopathogenic fungi from hibernating sites of Sunn Pest (Eurygaster integriceps) on Ilam Mountains, Iran. Int. J. Curr. Microbiol. Appl. Sci. 2014, 3, 314–325. [Google Scholar]
- Sönmez, E.; Demİrbağ, Z.; Demir, I. Pathogenicity of selected entomopathogenic fungal isolates against the oak lace bug, Corythucha arcuata Say.(Hemiptera: Tingidae), under controlled conditions. Turk. J. Agric. For. 2016, 40, 715–722. [Google Scholar]
- Inglis, G.D.; Goettel, M.S.; Butt, T.M.; Strasser, H. Use of hyphomycetous fungi for managing insect pests. Fungi Biocontrol Agents 2001, 1, 23–69. [Google Scholar]
- Asma, Z.; Ahmed, M.; Ayberk, H.; Qiu, B.; Cuthbertson, A.; Varlese, R.; Lombardi, N.; Mannion, C.; Daami-Remadi, M.; Braham, M. Occurrence, Characterization and Pathogenicity Test of the Fungi, Aspergillus flavus and Fusarium oxysporum Isolated from Cadavers of Scolytus amygdale Guerin-Meneville (Coleoptera: Curculionidae: Scolytinae). Egypt. J. Biol. Pest Control 2017, 27, 177–188. [Google Scholar]
- Khan, S.; Guo, L.; Maimaiti, Y.; Mijit, M.; Qiu, D. Entomopathogenic fungi as microbial biocontrol agent. Mol. Plant Breed. 2012, 3, 63–79. [Google Scholar] [CrossRef]
- Santos, T.S.; Freitas, A.C.D.; Poderoso, J.C.M.; Hernandez-Macedo, M.L.; Ribeiro, G.T.; Costa, L.P.D.; Mendonça, M.D.C. Evaluation of Isolates of Entomopathogenic Fungi in the Genera Metarhizium, Beauveria, Isaria, and Their Virulence to Thaumastocoris Peregrinus (Hemiptera: Thaumastocoridae); SPIE: Kissimmee, FL, USA, 2018; Volume 101, p. 6. [Google Scholar]
- Wicklow, D.T.; Dowd, P.F.; TePaske, M.; Gloer, J. Sclerotial metabolites of Aspergillus flavus toxic to a detritivorous maize insect (Carpophilus hemipterus, Nitidulidae). Trans. Br. Mycol. Soc. 1988, 91, 433–438. [Google Scholar] [CrossRef]
- Ferron, P. Biological control of insect pests by entomogenous fungi. Annu. Rev. Entomol. 1978, 23, 409–442. [Google Scholar] [CrossRef]
- Khan, S.; Nadir, S.; Lihua, G.; Xu, J.; Holmes, K.A.; Dewen, Q. Identification and characterization of an insect toxin protein, Bb70p, from the entomopathogenic fungus, Beauveria bassiana, using Galleria mellonella as a model system. J. Invertebr. Pathol. 2016, 133, 87–94. [Google Scholar] [CrossRef] [PubMed]
- Gopal, M.; Gupta, A.; Nair, K.R.C.; Sathiamma, B.; Nair, C.P.R. Studies on cross-infectivity with entomofungal isolates of A. flavus Link. against Stephanitis typica and Opisina arenosella, two pests of coconut. Indian Coconut J. 2000, 31, 12–15. [Google Scholar]
- Nowierski, R.M.; Zeng, Z.; Jaronski, S.; Delgado, F.; Swearingen, W. Analysis and Modeling of Time-Dose-Mortality of Melanoplus sanguinipes, Locusta migratoria migratorioides, and Schistocerca gregaria (Orthoptera: Acrididae) from Beauveria, Metarhizium, and Paecilomyces Isolates from Madagascar. J. Invertebr. Pathol. 1996, 67, 236–252. [Google Scholar] [CrossRef]
- Loureiro, E.D.S.; Moino, A., Jr. Pathogenicity of hyphomycete fungi to aphids Aphis gossypii Glover and Myzus persicae (Sulzer) (Hemiptera: Aphididae). Neotrop. Entomol. 2006, 35, 660–665. [Google Scholar] [CrossRef]
- Saranya, S.; Ushakumari, R.; Jacob, S.; Philip, B.M. Efficacy of different entomopathogenic fungi against cowpea aphid, Aphis craccivora (Koch). J. Biopestic. 2010, 3, 138. [Google Scholar]
- Ekesi, S.; Akpa, A.D.; Onu, I.; Ogunlana, M.O. Entomopathogenicity of Beauveria bassiana and Metarhizium anisopliae to the cowpea aphid, Aphis craccivora Koch (Homoptera: Aphididae). Arch. Phytopathol. Plant Prot. 2000, 33, 171–180. [Google Scholar] [CrossRef]
- Shah, F.A.; Wang, C.S.; Butt, T.M. Nutrition influences growth and virulence of the insect-pathogenic fungus Metarhizium anisopliae. Fems Microbiol. Lett. 2005, 251, 259–266. [Google Scholar] [CrossRef]
- Roy, H.E.; Pell, J.K. Interactions between entomopathogenic fungi and other natural enemies: Implications for biological control. Biocontrol Sci. Technol. 2000, 10, 737–752. [Google Scholar] [CrossRef]

| Isolates | Growth Morphology | Colony Color | Phialides Organization | Conidia Shape | Conidia Size (µm) | Probable Fungus | Strain Number | Reference | Molecular Identity | Identity % | Accession No. |
|---|---|---|---|---|---|---|---|---|---|---|---|
| F1 | Luxuriant mycelium which becomes folded as culture ages | Peach with purple trace, whitish spots | Simple lateral | Oval, cylindrical, ellipsoidal to macro and microconidia | 3.8–6.6 × 1.5–3.4 | Fusarium proliferatum | BAMF2c | [47] | Fusarium proliferatum | 100 | GQ505459.1 |
| F2 | Fast growing | Green | Biseriate and radiate | Rough and globose | 3–5.5 × 2.4–2.9 | Aspergillus tamarii | BAMF2d | [48] | Aspergillus tamarii | 99 | LC127424.1 |
| F3 | Rapid growth and densely sporulated | Dirty green | Naturally radiate | Classically globose to subglobose | 3.5–5.2 × 2.2–2.8 | A. flavus | BAMF2a | [49] | A. flavus | 100 | MF319893.1 |
| F4 | Rapid growth, greyish | Glaucous to dark green | Verticillate, solitary, lageniform, and curved | Smooth, dark green, sub globose when fully mature | 35–7 × 2.5–3.5 | Trichoderma atroviride | BAMF2e | [50] | Trichoderma atroviride | 100 | KU896311.1 |
| F5 | Rapid growth and conidiation | Black | Biseriate | Coarse, echinulate and globose | 4–6 × 2.7–3.8 | A. niger | BAMF2b | [49] | A. niger | 100 | KY657577.1 |
| Ref. | Rapid growth and conidiation | Dark-herbage green | Cylindrical and podgy | Colorless, Ellipsoidal, rounded apex, slightly truncate base | 4.8–6.1 × 2.2–3.6 | M. anisopliae | [41,51] | M. anisopliae |
| Isolate | Name of Species | Number of Isolates | Mean Conidial Viability (%) ± S.E | Reports of Pathogenicity Against Insects |
|---|---|---|---|---|
| F1 | Fusarium proliferatu | 6 | 94 ± 0.33a | [52] |
| F2 | A. tamarii | 4 | 93 ± 0.88a | [48] |
| F3 | A. flavus | 11 | 97 ± 0.88a | [15,22,49,53] |
| F4 | Trichoderma atroviride | 3 | 90 ± 0.33a | Mostly used for the competitive exclusion of plant pathogens. |
| F5 | A. niger | 8 | 95 ± 0.33a | [49,54] |
| Ref | M. anisopliae * | 96 ± 0.33a | [32,34,49,55] |
| Isolate | Name of Species | Mean Mortality ± S.E | |||||
|---|---|---|---|---|---|---|---|
| Day 2 | Day 4 | Day 6 | Day 8 | Day 10 | Control | ||
| F1 | Fusarium proliferatum | 3.33 ± 0.88 | 15.67 ± 1.76 | 8.33 ± 0.67 | 9.67 ± 1.45 | 2.67 ± 0.33 | 3.34 ± 0.15 |
| F2 | A. tamarii | 2.00 ± 2.08 | 13.33 ± 1.86 | 12.33 ± 1.20 | 6.67 ± 2.67 | 2.67 ± 0.67 | 2.33 ± 0.33 |
| F3 | A. flavus | 3.67 ± 1.76 | 25.67 ± 0.33 | 10.00 ± 0.58 | 1.33 ± 0.88 | 0.00 ± 0.00 | 1.67 ± 0.33 |
| F4 | T. atroviride | 3.67 ± 1.67 | 10.67 ± 1.33 | 10.00 ± 1.53 | 8.00 ± 1.15 | 5.33 ± 0.88 | 2.33 ± 0.33 |
| F5 | A. niger | 2.33 ± 1.20 | 15.00 ± 2.31 | 11.00 ± 0.58 | 6.00 ± 1.53 | 2.00 ± 1.16 | 2.67 ± 0.56 |
| Ref. | M. anisopliae | 4.00 ± 0.58 | 29.33 ± 1.76 | 16.30 ± 1.86 | 1.37 ± 0.00 | 0.00 ± 0.00 | 3.86 ± 0.78 |
| Isolate | LC50Conidia/mL | 95% Fiducial Limits | LC90 | 95% Fiducial Limits | ||
|---|---|---|---|---|---|---|
| Lower | Upper | Lower | Upper | |||
| A. flavus F3 | 6.75 × 106 | 1.38 × 106 | 4.11 × 107 | 4.42 × 109 | 1.01 × 109 | 2.57 × 1012 |
| M. anisopliae | 8.0 × 106 | 1.41 × 106 | 1.2 × 107 | 6.14 × 108 | 2.54 × 108 | 1.76 × 109 |
| Isolate | LT50 (Days) | 95% Fiducial Limits | LT90 (Days) | 95% Fiducial Limits | ||
|---|---|---|---|---|---|---|
| Lower | Upper | Lower | Upper | |||
| A. flavus F3 | 3.3 | 1.3 | 4.6 | 6.2 | 5.9 | 7.1 |
| M. anisopliae | 3.6 | 1.6 | 4.7 | 5.6 | 5.3 | 7.3 |
© 2020 by the authors. Licensee MDPI, Basel, Switzerland. This article is an open access article distributed under the terms and conditions of the Creative Commons Attribution (CC BY) license (http://creativecommons.org/licenses/by/4.0/).
Share and Cite
Umaru, F.F.; Simarani, K. Evaluation of the Potential of Fungal Biopesticides for the Biological Control of the Seed Bug, Elasmolomus pallens (Dallas) (Hemiptera: Rhyparochromidae). Insects 2020, 11, 277. https://doi.org/10.3390/insects11050277
Umaru FF, Simarani K. Evaluation of the Potential of Fungal Biopesticides for the Biological Control of the Seed Bug, Elasmolomus pallens (Dallas) (Hemiptera: Rhyparochromidae). Insects. 2020; 11(5):277. https://doi.org/10.3390/insects11050277
Chicago/Turabian StyleUmaru, Fredrick Fidelis, and Khanom Simarani. 2020. "Evaluation of the Potential of Fungal Biopesticides for the Biological Control of the Seed Bug, Elasmolomus pallens (Dallas) (Hemiptera: Rhyparochromidae)" Insects 11, no. 5: 277. https://doi.org/10.3390/insects11050277
APA StyleUmaru, F. F., & Simarani, K. (2020). Evaluation of the Potential of Fungal Biopesticides for the Biological Control of the Seed Bug, Elasmolomus pallens (Dallas) (Hemiptera: Rhyparochromidae). Insects, 11(5), 277. https://doi.org/10.3390/insects11050277





